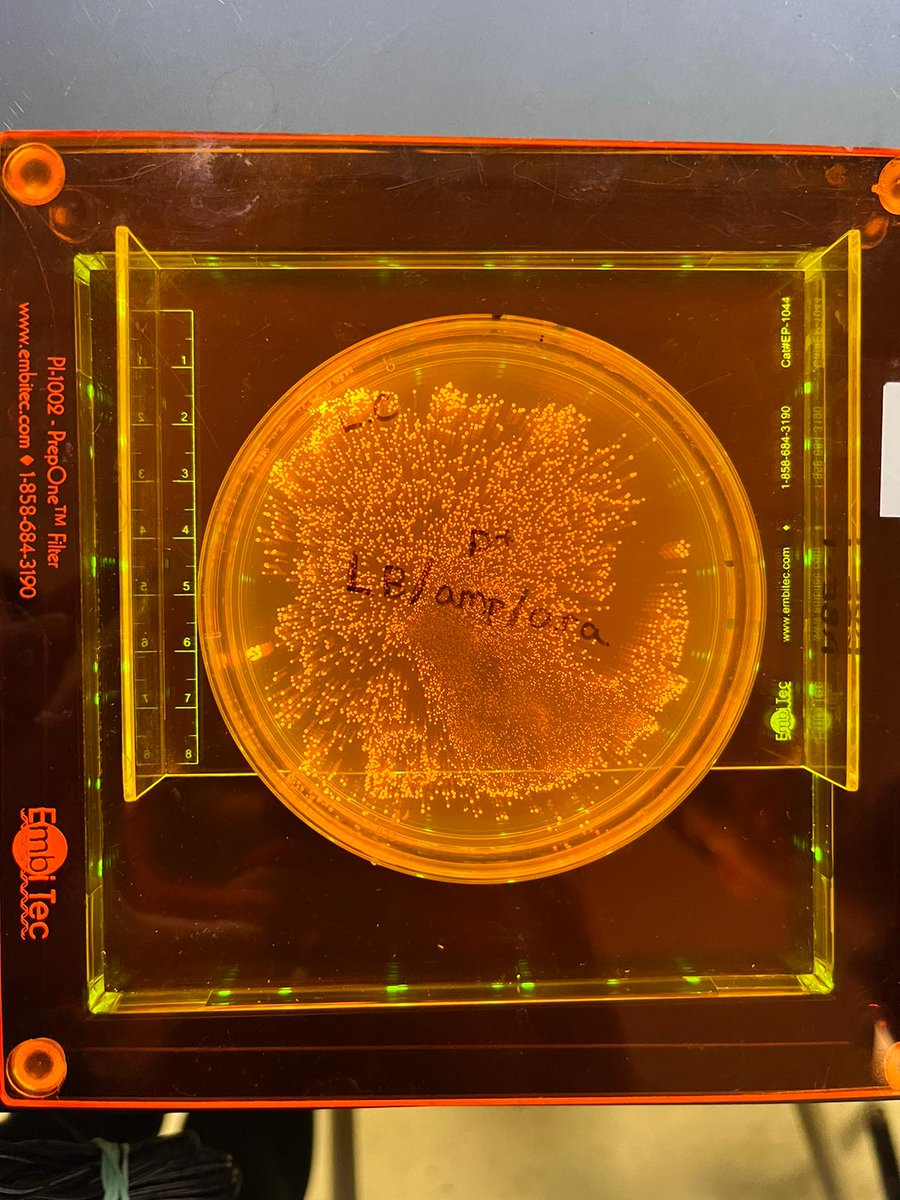
Sarah Gallah tweet media

Sabitlenmiş Tweet

Exciting news! I’ve been selected as a 2021 Grosvenor Teacher Fellow with National Geographic & Lindblad Expeditions. So honoured to be part of this inspiring community of explorers and educators!
@InsideNatGeo @LindbladExp
@NatGeoEducation @smchoirschool @tcdsb
#GTF2021

English